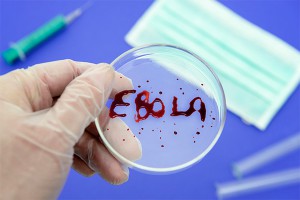
Испания боится зараженных Эболой солдат США Испания боится зараженных Эболой солдат США

10 октября, четверг | ![]() ![]() ![]() |
![]() | ПОЛИТИКА | ЭКОНОМИКА | ОБЩЕСТВО | ПРОИСШЕСТВИЯ | КУЛЬТУРА | СПОРТ | МЕДИА | В МИРЕ | АВТО | ТЕХНОЛОГИИ | ![]() |
| Фоторепортажи | Видеосюжеты | Комментарии | Погода | Работа | Форум | Карта | Подписка и RSS | Реклама| О газете |
Испания боится зараженных Эболой солдат США31 октября 2014, пятница, 19:46 – БРЯНСК.RU | Комментарии: 0
| Версия для печати Около четырех тысяч американских военнослужащих, которые направлены правительством США в страны Африки для борьбы с вирусом Эбола, смогут вернуться домой через территорию Испании. В испанском обществе такое решение вызвало волну критики в адрес правительства. Простые жители страны опасаются, что американцы могут завезти опасную лихорадку в Испанию.Как отмечает ТАСС, настоящую панику решение пустить солдат из стран, где распространяется вирус, вызвало в регионе Андалусиа. Дело в том, что именно здесь расположены американские военно-воздушные базы, через которые и планируется переправлять американцев домой. Дело дошло до того, что вопрос о разрешении транзита вынесли на обсуждение в испанском парламенте. Результатом слушаний стало согласие на допуск американцев лишь в том случае, если они пройдут предварительный карантин в одной из стран Африки, где Эбола не зафиксирована. Как отметил министр обороны Испании, скорее всего, это будет Сенегал. Как ранее писали Дни.Ру, США направили четыре тысячи военных в Либерию, чтобы погасить вирус Эбола в регионе. Американцы намерены заняться строительством временных больниц. Планируется, что солдаты будут доставлять в разбитый полевой госпиталь местных врачей, если те вдруг заболеют смертельно опасной лихорадкой. Между тем вирус Эбола постепенно распространяется по Европе. Недавно первый человек с подозрениями на заболевание лихорадкой Эбола появился в Финляндии. Пациент побывал в регионе эпидемии – в Либерии, в настоящее время он помещен в столичную инфекционную больницу Мейлахти. За медицинской помощью он обратился в связи с головными болями и температурой. Источник:
|
![]() | ПОЛИТИКА | ЭКОНОМИКА | ОБЩЕСТВО | ПРОИСШЕСТВИЯ | КУЛЬТУРА | СПОРТ | МЕДИА | В МИРЕ | АВТО | ТЕХНОЛОГИИ | ![]() |
| Фоторепортажи | Видеосюжеты | Комментарии | Погода | Работа | Форум | Карта | Подписка и RSS | Реклама| О газете |
| Размещение рекламы в газете БРЯНСК.RU: Прайс-лист, тел. (4832) 37-19-38, почта info@briansk.ru Для информационных писем в редакцию: news@briansk.ru | ![]() | ![]() | ||
| 2005–2015 © Ежедневная интернет-газета БРЯНСК.RU При цитировании активная ссылка на БРЯНСК.RU обязательна Материалы газеты могут содержать информацию 18+ | ![]() | Открыв данный сайт, Вы соглашаетесь с Правилами cайта (договор-оферта). Если вы не согласны с Правилами, немедленно покиньте сайт! | ![]() |

В глубине экрана: Мастер-класс по ремонту телевизоров
Погружение в мир футбола онлайн: для поклонников Игры
Займ без проверок
Тотализаторы: что это такое и чем они отличаются от обычных ставок?
Играть в бесплатные игровые автоматы в онлайн-клубе Вулкан
Стоит ли посещать офтальмолога при замене очков?
Успешные игроки предпочитают игровые автоматы Вулкан
Новое казино Супер Слотс поможет воплотить ваши мечты в реальность







ПОПУЛЯРНЫЕ МАТЕРИАЛЫ










